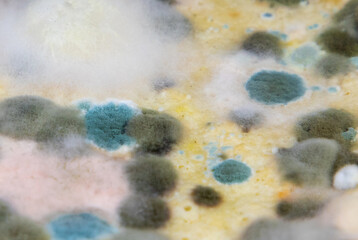
Mold on spoiled food. Various types of fungi grown on food

★★★★★
obrazy jak na zdjęciu wszystko zgodne z…
obrazy jak na zdjęciu wszystko zgodne z opisem polecam szybka wysyłka
Mariola Pyka
★ ★★★★
Poprzednio
Poprzednio - dostawa super i na czas. Moje drugie (aktualne) zamówienie do tej pory nie zostało doręczone, a minęła znacznie więcej niż 4 dni robocze. Jestem rozczarowany!
Józef Pachałko
★★★★★
Szybką dostawą,duży wybór
Szybką dostawą,duży wybór
Urszula Karbownik
★★★★★
Mega zadowolona
Dziękuję bardzo za wykonanie mojego zlecenia. Jestem bardzo zadowolona I polecam z korzystania z Waszych usług.
Ewa Andrzejewska